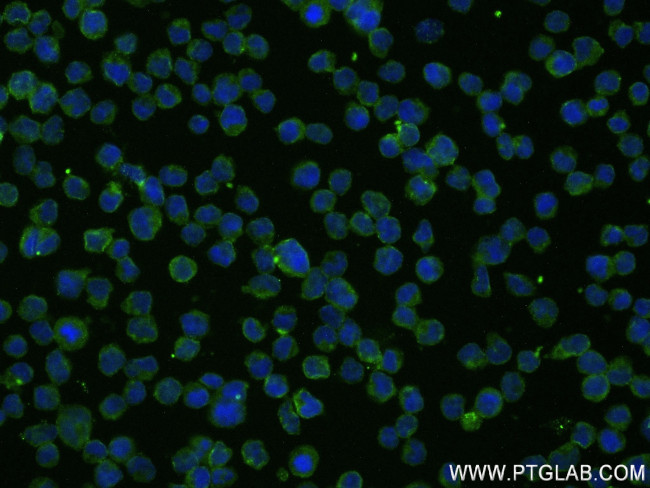
B7H6 Antibody in Immunocytochemistry (ICC/IF)
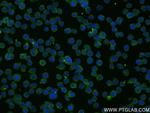
B7H6 Antibody in Immunocytochemistry (ICC/IF)

Search
Proteintech
B7H6 Recombinant Rabbit Monoclonal Antibody (240808B2)
{{$productOrderCtrl.translations['antibody.pdp.commerceCard.promotion.promotions']}}
{{$productOrderCtrl.translations['antibody.pdp.commerceCard.promotion.viewpromo']}}
{{$productOrderCtrl.translations['antibody.pdp.commerceCard.promotion.promocode']}}: {{promo.promoCode}} {{promo.promoTitle}} {{promo.promoDescription}}. {{$productOrderCtrl.translations['antibody.pdp.commerceCard.promotion.learnmore']}}
产品信息
83908-4-RR
种属反应
宿主/亚型
Expression System
分类
类型
克隆号
抗原
偶联物
形式
浓度
纯化类型
保存液
内含物
保存条件
运输条件
靶标信息
B7-H6 (NCR3LG1) is a transmembrane endogenous ligand expressed on the surfaces of tumor cells. B7-H6 binds with NKp30 present on NK cells. Binding of B7-H6 to NKp30 causes the ligation of NKp30 subsequently inducing NK cell activation and target cell cytolysis. B7-H6 is not constitutively expressed on normal tissue. Whether it can be expressed endogenously under certain conditions is under investigation. B7-H6 has been detected on circulating pro-inflammatory CD14(+)CD16(+) monocytes in some patients with sepsis.
仅用于科研。不用于诊断过程。未经明确授权不得转售。
篇参考文献 (0)
生物信息学
蛋白别名: B7 homolog 6; B7-H6; DKFZp686I21167; Natural cytotoxicity triggering receptor 3 ligand 1; putative Ig-like domain-containing protein DKFZp686O24166/DKFZp686I21167
基因别名: B7-H6; B7H6; DKFZp686O24166; NCR3LG1
UniProt ID: (Human) Q68D85
Entrez Gene ID: (Human) 374383